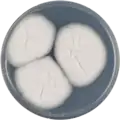
Aspergillus spinosus growing on CYA plate

| Aspergillus spinosus | |
|---|---|
| Scientific classification | |
| Domain: | Eukaryota |
| Kingdom: | Fungi |
| Division: | Ascomycota |
| Class: | Eurotiomycetes |
| Order: | Eurotiales |
| Family: | Aspergillaceae |
| Genus: | Aspergillus |
| Species: | A. spinosus |
| Binomial name | |
| Aspergillus spinosus Kozakiewicz 1989[1] | |
| Type strain | |
| ATCC 16898, CBS 483.65, NRRL 5034[2] | |
| Synonyms | |
|
Aspergillus fischeri var. spinosus,[2] | |
Aspergillus spinosus is a species of fungus in the genus Aspergillus.[3][1][2] Aspergillus spinosus produces aszonalenins, 2-pyrovoylaminobenzamide, fumigachlorin and pseurotins.[4]
Growth and morphology
A. spinosus has been cultivated on both Czapek yeast extract agar (CYA) plates and Malt Extract Agar Oxoid® (MEAOX) plates. The growth morphology of the colonies can be seen in the pictures below.
Aspergillus spinosus growing on CYA plate
Aspergillus spinosus growing on CYA plate Aspergillus spinosus growing on MEAOX plate
Aspergillus spinosus growing on MEAOX plate
References
- 1 2 "Aspergillus spinosus". MycoBank. Retrieved 1 January 2018.
- 1 2 3 4 5 6 "Aspergillus spinosus". UniProt. Retrieved 4 January 2018.
- ↑ "Aspergillus spinosus Kozak". www.gbif.org.
- ↑ Lamoth, Frederic; Steinbach, William J. (2016). Advances in Aspergillus fumigatus pathobiology. Frontiers Media SA. ISBN 9782889197897.
Further reading
- Powell, Keith A.; Renwick, Annabel; Peberdy, John F. (2013). The Genus Aspergillus: From Taxonomy and Genetics to Industrial Application. Springer Science & Business Media. ISBN 9781489909817.
This article is issued from Wikipedia. The text is licensed under Creative Commons - Attribution - Sharealike. Additional terms may apply for the media files.